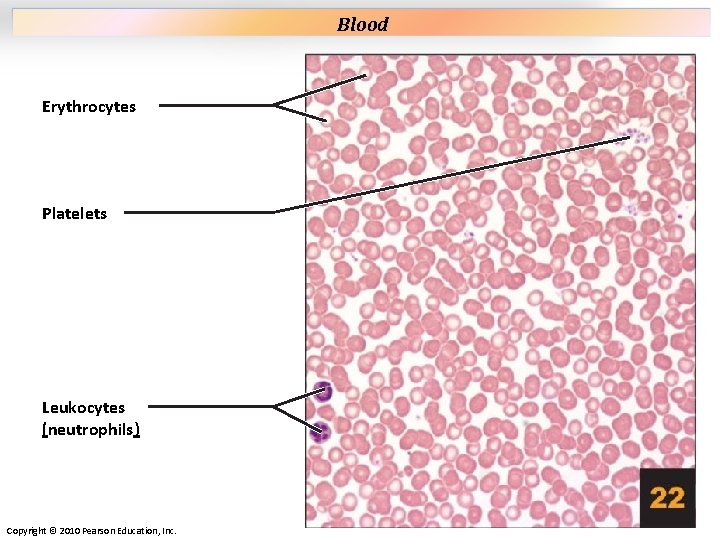
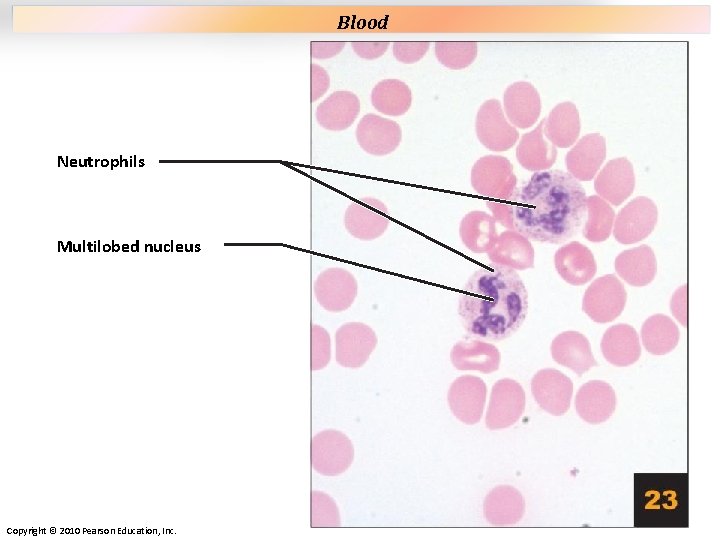
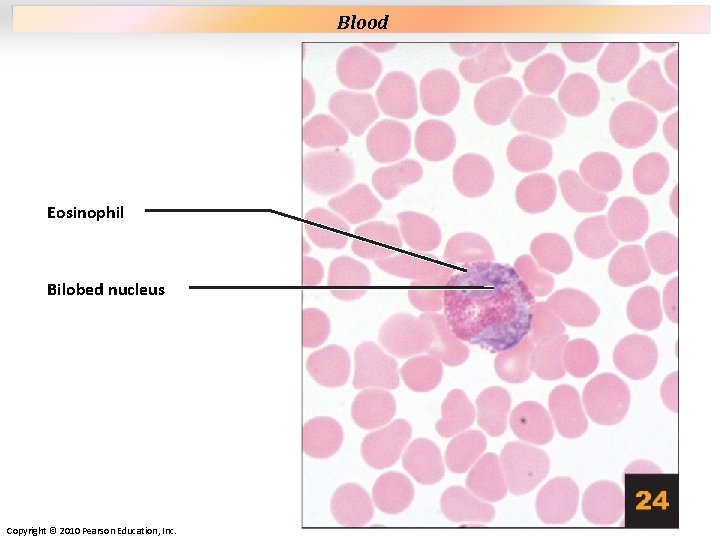
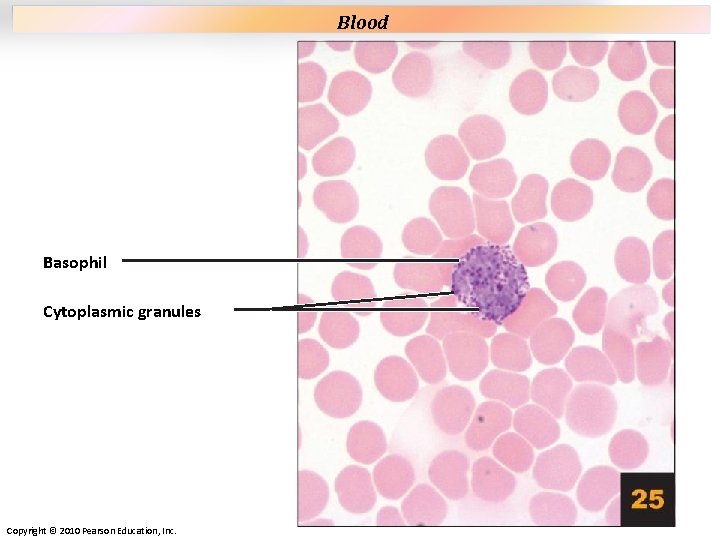
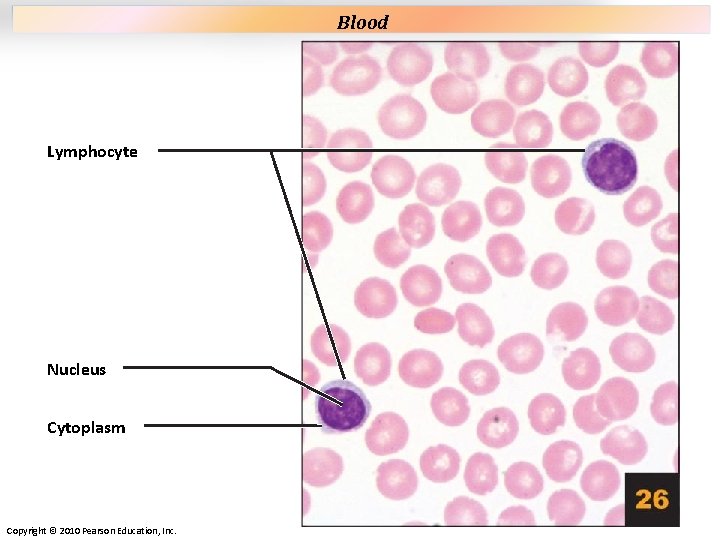
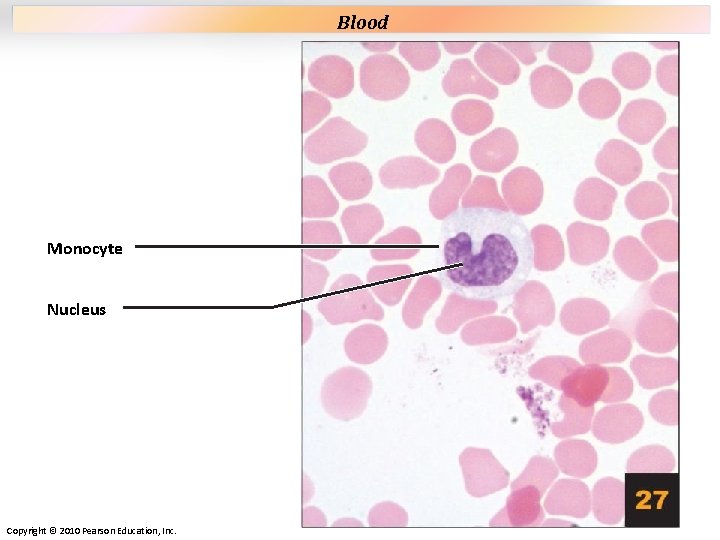

LAB OUTLINE Lab will consist of 2 sections

LAB OUTLINE • Lab will consist of 2 sections 1. Section 1 – Tissues (2 ½ weeks) 2. Section 2 – Bone + Muscle (6 ½ weeks) • 2 lab practicals – practical end of each section – Tissue, terminology, and body orientation practical will be projected as power points as presented in lab and online – Bone & Muscle practical will be on bone and muscle specimen and models in lab.

TISSUES Part 1 of 3 Lab Sections

EPITHELIAL TISSUE

Plate 1 Simple Squamous Epithelium – flat section/view from above Cell nucleus Cytoplasm Plasma membrane Copyright © 2010 Pearson Education, Inc.

Plate 2 Simple Squamous Epithelium – cross section Simple squamous epithelium Cell nucleus Copyright © 2010 Pearson Education, Inc.

Plate 3 Simple cuboidal epithelium Lumen of renal tubule Epithelial cell nucleus Copyright © 2010 Pearson Education, Inc. Simple Cuboidal Epithelium

Plate 4 Simple columnar epithelium Nucleus Microvilli Goblet cell secreting mucus Lamina propria Copyright © 2010 Pearson Education, Inc. Simple Columnar Epithelium

Plate 5 Simple Columnar Epithelium with cilia Ciliated simple columnar epithelium Nucleus Lumen of uterine tube Cilia Copyright © 2010 Pearson Education, Inc.

Pseudostratified Columnar Epithelium Plate 6 Pseudostratified columnar epithelium Nuclei Goblet cell Cilia Copyright © 2010 Pearson Education, Inc.

Plate 7 Apical cells Stratified squamous epithelium Basal cells Cell nuclei Connective tissue Copyright © 2010 Pearson Education, Inc. Stratified Squamous Epithelium

Plate 8 Stratified cuboidal epithelium Lumen of duct Cell nuclei Connective tissue Sweat gland Copyright © 2010 Pearson Education, Inc. Stratified Cuboidal Epithelium

Plate 9 Stratified columnar epithelium Columnar apical cell Cuboidal basal cell Cell nuclei Lumen of duct Connective tissue Copyright © 2010 Pearson Education, Inc. Stratified Columnar Epithelium

Plate 10 Lumen of ureter Cuboidal shaped cells Transitional epithelium Connective tissue Copyright © 2010 Pearson Education, Inc. Transitional Epithelium

Plate 11 Nuclei of fibroblasts Collagen fiber Elastic fibers Gel-like ground substance Mast cell Copyright © 2010 Pearson Education, Inc. Areolar Tissue

Plate 12 Cell nucleus of an adipocyte Adipocytes Fat droplet within an adipocyte Blood vessel Copyright © 2010 Pearson Education, Inc. Adipose Tissue

Plate 13 Reticular fibers Gel-like ground substance Copyright © 2010 Pearson Education, Inc. Reticular Tissue

Plate 14 Nuclei of fibroblasts Collagen fibers Copyright © 2010 Pearson Education, Inc. Dense Irregular Connective Tissue

Plate 15 Regularly aligned collagen fibers Nuclei of fibroblasts Copyright © 2010 Pearson Education, Inc. Dense Regular Connective Tissue

Plate 16 Lumen of aorta Elastic fibers Copyright © 2010 Pearson Education, Inc. Elastic Tissue

Plate 17 Matrix Chondrocyte in a lacuna Lacuna Perichondrium Copyright © 2010 Pearson Education, Inc. Hyaline Cartilage

Plate 18 Chondrocyte in a lacuna Elastic fibers Gelatinous ground substance Copyright © 2010 Pearson Education, Inc. Elastic Cartilage

Plate 19 Chondrocyte in a lacuna Collagen fibers Copyright © 2010 Pearson Education, Inc. Fibrocartilage

Plate 20 Lamellae Osteon Central canal Osteocytes in lacunae Canaliculi extending through matrix Copyright © 2010 Pearson Education, Inc. Compact Bone

Plate 21 Red bone marrow Trabecula Osteocytes within lacunae Osteoblasts Osteoclasts Copyright © 2010 Pearson Education, Inc. Spongy Bone
Plate 22 Erythrocytes Platelets Leukocytes (neutrophils) Copyright © 2010 Pearson Education, Inc. Blood
Plate 23 Neutrophils Multilobed nucleus Copyright © 2010 Pearson Education, Inc. Blood
Plate 24 Eosinophil Bilobed nucleus Copyright © 2010 Pearson Education, Inc. Blood
Plate 25 Basophil Cytoplasmic granules Copyright © 2010 Pearson Education, Inc. Blood
Plate 26 Lymphocyte Nucleus Cytoplasm Copyright © 2010 Pearson Education, Inc. Blood
Plate 27 Monocyte Nucleus Copyright © 2010 Pearson Education, Inc. Blood

MUSCLE

Plate 28 Muscle fiber Nuclei A band I band Z disc Copyright © 2010 Pearson Education, Inc.

Plate 29 Perimysium surrounding a fascicle Blood vessels Muscle fibers Nuclei of muscle fiber Copyright © 2010 Pearson Education, Inc.

Plate 30 Skeletal muscle fiber Axon of motor neuron Axon terminals at neuromuscular junctions Terminal branches Copyright © 2010 Pearson Education, Inc.

Plate 31 Nucleus Striations Intercalated discs Cardiac muscle cell Copyright © 2010 Pearson Education, Inc.

Plate 32 Smooth muscle cell Cell nucleus Group of smooth muscle cells in cross section Copyright © 2010 Pearson Education, Inc.

NEURON

Plate 33 Nucleus Nucleolus Cell processes Neuroglia Copyright © 2010 Pearson Education, Inc.

MISCELLANEOUS – PRACTICE

Plate 37 Name the different tissues Stratified Squamous Epithelium Stratum corneum – consisting of keratin Stratum lucidum Stratum granulosum Stratum spinosum Stratum basale Papillary layer Areolar Tissue Meissner’s corpusule Reticular layer Dense Irregular CT Simple Squamous Epithelium Collagen fibers Copyright © 2010 Pearson Education, Inc.

Name the different tissues Plate 40 Mucosa Pseudostratified columnar epithelium with cilia Goblet cell with mucus Ciliated epithelium Lamina propria Submucosa Stratified cuboidal epithelium Seromucosal gland Hyaline cartilage ring Hyaline cartilage Copyright © 2010 Pearson Education, Inc.

Name the different tissues Plate 44 Lumen Mucosa Simple Columnar Epithelium Intestinal glands Villus Muscularis mucosa Submucosa Muscularis externa Circular layer Longitudinal layer Serosa Copyright © 2010 Pearson Education, Inc. Smooth muscle

Name the different tissues Plate 45 Villus Simple columnar epithelium Goblet cells Lamina propria Intestinal glands Muscularis mucosa Copyright © 2010 Pearson Education, Inc. Smooth muscle

Name the different tissues Plate 48 Renal corpuscle Capsular space Simple squamous epithelium Glomerular capillaries Parietal layer of glomerular capsule Juxtaglomerular apparatus Juxtaglomerular cells Macula densa Proximal convoluted tubules Distal convoluted tubule Copyright © 2010 Pearson Education, Inc. Simple cuboidal epithelium

Plate 49 Name the different tissues Collecting duct Simple cuboidal epithelium Thin segment of loop of Henle Copyright © 2010 Pearson Education, Inc.

Name the different tissues Plate 50 Lumen of the bladder Transitional epithelium Mucosa Transitional epithelium Areolar connective tissue Lamina propria Smooth muscle Detrusor muscle Copyright © 2010 Pearson Education, Inc.

Name the different tissues Plate 52 Stratified cuboidal epithelium Antrum Copyright © 2010 Pearson Education, Inc. Granulosa cells Secondary oocyte Corona radiata

Plate 54 Name the different tissues Colloid filled follicles Follicle cells Simple cuboidal epithelium Copyright © 2010 Pearson Education, Inc.
- Slides: 48